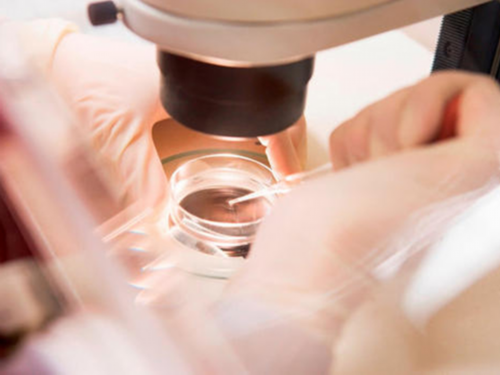
绝经后借卵能不能做试管_借卵试管选性别_试管婴儿微刺激方案过程全介绍，你

2023-05-19 12:20点击: 519
卵子是试管婴儿手术中最重要的一个环节,很多女性朋友在取卵之前会很担忧,担心取卵对卵巢造成伤害,也担心取卵的过程会不会很痛苦。那么取卵前后有哪些事情需要我们注意呢?
取卵术前应注意什么:
1、饮食清淡,在取卵的那天,无痛取卵不能吃早餐,如果不打麻醉可以吃点食物,而食物方面要以固体食物为主,一定要少喝牛奶以及豆浆这些流食。
2、促排卵期间,禁止同房。
3、取卵前1个月,夫妻双方就应该停止抽烟、喝酒、熬夜等不良生活习惯。
取卵术后应注意什么:
1、取卵术后卧床休息,第一次下床活动或如厕时家属陪同,慎防跌倒。
2、麻醉未清醒前请勿进食,清醒后请进食清淡易消化食物。
3、麻醉后24小时内禁止驾车等机械操作。
4、取卵术后轻翻身活动,避免剧烈运动。
5、如出现腹痛、胃痛、阴道出血、少尿现象,请到医院就诊。
取卵后有些血性内分泌物正常吗:
如果在取卵或移植后出现血性内分泌物,不用太担心,如果出现腹疼加重、阴道出血多,请及时到医院就诊。
取卵后这三类食物不宜食用:
1、活血化瘀、祛湿排毒的食物不能吃:如补药、藕、麻油、西洋菜、黑木耳、桂圆、苡仁米、烟、酒、咖啡、茶叶。
2、寒凉食物不能吃:如水梨、瓜类、柑橘、柳橙、甘蔗、番茄、火龙果、釉子、硬柿子、菠萝、梨子、奇异果、桑葚、山竹、木瓜、香蕉、芥菜、白菜、芹菜、苦瓜、冬瓜、藕等可退火的食物都不能吃。
3、破坏子宫内膜的食物不能吃:取卵后,苹果、柠檬、番茄等食物不能,另外在移植24小时内不要提重物;不要喝含酒精的饮料;不要使用止痛或者镇静之类的药物;按医嘱按时吃药。
试管婴儿属于医疗范围,无论多大年龄或身体素质如何,小编建议都应该听从医嘱,按时服用药物,切勿自己减少用量或停止用药,免得因一时的失误给身体带来伤害。
同时小编建议女性朋友取卵后切勿使用盆浴或泡澡等,表面滋生感染,最好选择淋浴。在取卵后身体出现明显不适或其他异常情况,建议最好到医院就诊。
微刺激方案是目前在试管婴儿期间使用比较频繁的一种促排方案,在治疗期间,它对女性的卵巢刺激更小,同时用药量也少,是很多患者都接受的一种促排方案。今天我们就一起来了解一下微刺激方案的具体流程。
对于微刺激方案,相信大家也都有了大致的了解,此方案的治疗周期一般是8-10天左右。此方案和拮抗剂方案一样,都没有降调过程,所以在流程上会比其他方案简单一些,而且用药也没有那么复杂。
在临床上,微刺激方案的流程一般是月经来潮第3-5天开始促排,整个用药时间大概是8-10天左右,等到卵泡生长到直径17-18mm后,再进行绒毛膜促性腺激素夜针,过36小时之后安排取卵。
试管婴儿微刺激方案的费用本身就低,因为用药主要是应用小剂量药物促使卵泡生长,其中包括单用口服促排药物或小剂量促排卵针剂,又或者是联合使用两者,而针剂使用剂量一般不会超过150u/日。
微刺激方案一般会在月经第二天开始监测卵泡和检查性激素六项,检查结果达标则会在月经第二天服用法地兰,直到收针为止。微刺激方案的用药剂量比较小,不吃阿司匹林也可以,卵泡大于14mm时就要通知男方排精,以便后期取精与卵子受精。
前面也说过,微刺激方案并没有降调节这个环节,它相比于其他常规方案而言,微刺激方案促排的时间较短,而且获得的卵子数量也较少,一般有1-6个为多见。
所以,对于那些有特殊情况的患者来说,选择微刺激方案促排是一个不错的选择。特别是卵巢储备减少的患者,选择此方案的效果更佳,因为它可以降低药物的副作用,同时降低了试管周期的整个成本。
正常情况,微刺激方案一般都是在8天内完成,其最大的优点就是用时少、安全、药费低、不会发生卵巢过度刺激综合征等。不过,微刺激方案有优点也有缺点,其缺点就是获卵数量较少一些。
目前为止,微刺激方案的适用人群是年龄大、卵巢功能下降、常规促排方案卵巢反应低下的患者,同时也应用于多囊卵巢综合征和发生过严重卵巢过度刺激综合征的患者。
无论使用什么样的促排方案,其实都有一定的适应症,所以,在选择方案前,各位患者要根据自己的情况和医生的建议考虑,不要盲目要求某种方案,以免影响成功率。
[试管龙凤胎婴儿多少钱][三代试管选性别准确率][试管婴儿性别可以选择吗][试管如何筛选性别][试管婴儿怎么都是龙凤胎吗][试管婴儿生龙凤胎的几率有多大][供精试管婴儿][试管能选择小孩性别吗]
泰国试管婴儿多少钱就选唯美加_供精试管婴儿家庭现状_厦门174医院做试管婴儿
(精度好的超声,5周多点就能看见)如果没有孕早期的B超报告,孕中晚期B超也会根据胎儿大
试管婴儿做男孩多少费用_供卵试管婴儿价格_长沙湘雅医院做试管婴儿要多少钱
长沙湘雅生殖医院做试管婴儿成功率在40%-50%之间,在全国也是前例的三甲医院,以及试管婴儿
第三代试管婴儿实施没有_三代试管婴儿费用多少钱_美国试管婴儿:子宫后位会
美国生殖专家说,单纯的子宫后位对试管助孕成功率的影响不大,因为在IVF周期中,生殖专家
3代试管婴儿也会畸形吗_3代试管婴儿也会畸形吗_【第三方辅助生殖】美国和俄
关键词:卵巢早衰做试管婴儿,辅助生殖技术助孕,卵巢储备功能降低佛山人工授精辅助生殖助孕